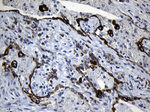
CISD2 Antibody in Immunohistochemistry (Paraffin) (IHC (P))

Search
OriGene
CISD2 Monoclonal Antibody (OTI4D12), TrueMAB™
{{$productOrderCtrl.translations['antibody.pdp.commerceCard.promotion.promotions']}}
{{$productOrderCtrl.translations['antibody.pdp.commerceCard.promotion.viewpromo']}}
{{$productOrderCtrl.translations['antibody.pdp.commerceCard.promotion.promocode']}}: {{promo.promoCode}} {{promo.promoTitle}} {{promo.promoDescription}}. {{$productOrderCtrl.translations['antibody.pdp.commerceCard.promotion.learnmore']}}
产品信息
TA810394
种属反应
宿主/亚型
分类
类型
克隆号
抗原
偶联物
形式
浓度
纯化类型
保存液
内含物
保存条件
运输条件
靶标信息
Defects in the CISD2 (CDGSH iron sulfur domain 2) gene are a cause of the neurodegenerative disorder Wolfram syndrome 2. CISD2 is a zinc finger protein that localizes to the endoplasmic reticulum and mitochondria and binds an iron/sulfur cluster. CISD2 interacts with Bcl-2 and can be displaced by the BH3-only protein BIK and contributes to the regulation of BIK-initiated autophagy. CISD2 deficiency in mice causes mitochondrial breakdown accompanied by autophagic cell death as well as the development of premature aging phenotype.
仅用于科研。不用于诊断过程。未经明确授权不得转售。
篇参考文献 (0)
生物信息学
蛋白别名: CDGSH iron-sulfur domain-containing protein 2; Endoplasmic reticulum intermembrane small protein; Miner1; mitoNEET related 1; MitoNEET-related 1 protein; NAF-1; Nutrient-deprivation autophagy factor-1; zinc finger, CDGSH-type domain 2
基因别名: CDGSH2; CISD2; ERIS; Miner1; NAF-1; WFS2; ZCD2
UniProt ID: (Human) Q8N5K1
Entrez Gene ID: (Human) 493856